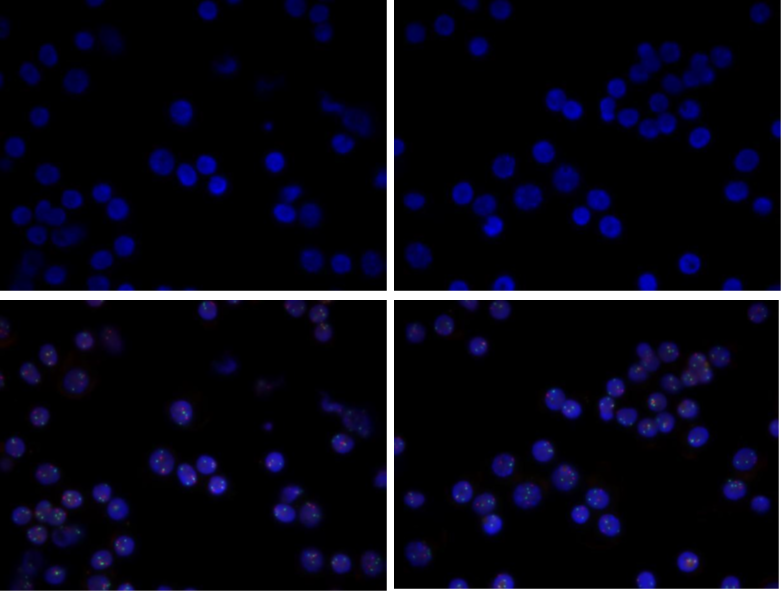
基于CD138免疫磁珠分选技术提升荧光原位杂交（FISH）的诊断效率的解决方案

10 年
手机商铺
公司新闻/正文
377 人阅读发布时间:2025-11-17 11:21
荧光原位杂交(FISH)是多发性骨髓瘤(MM)最主要的遗传学检测手段。然而,在实际检测中,MM患者骨髓中的肿瘤性浆细胞比例往往较低,其阳性信号易被大量正常细胞干扰,导致假阴性结果风险增高。因此,在FISH检测前对浆细胞进行富集,已成为提升诊断准确性的关键步骤。
CD138磁珠分选技术(MACS)是解决这一问题的有效方案。通过特异性结合CD138抗原,可从骨髓样本中高效富集CD138+浆细胞,为后续FISH检测提供高纯度的目标细胞群体。这一过程显著减少了非目标细胞造成的背景干扰,从而大幅提高了FISH检测的灵敏度与遗传学异常检出率。
2024年12月1日,中国医师协会血液科医师分会与中华医学会血液学分会共同发布了《2024版中国多发性骨髓瘤诊治指南》。在诊断检测部分,新版指南明确将荧光原位杂交(FISH)列为骨髓检查的推荐检测方法,并同时推荐采用CD138免疫磁珠分选技术,以提升诊断的准确性与规范性。

表1. 多发性骨髓瘤的检测项目
CD138细胞分选磁珠
为度生物提供的CD138细胞分选磁珠搭配细胞分选柱,可以对CD138+浆细胞进行分选,能够有效富集足够数量的目标细胞,确保后续基因检测的可行性,具有优异的细胞回收率、分选纯度及异常信号检测率,为提高多发性骨髓瘤的诊断精度、支持疾病研究与个体化治疗提供了重要技术支撑。

验证数据
1. CD138阳性细胞分离
在PBMC样本中添加U266人多发性骨髓瘤细胞系,验证CD138细胞的富集效果。

图1. 分选前后流式细胞图

结果显示,CD138细胞分选后纯度为93.13%,收率为83.3%,细胞分选效果较好。
2. FISH杂交实验结果
使用CD138分选磁珠从1–2 mL新鲜骨髓样本(保存于2–8℃,不超过24小时)中富集CD138细胞。随后使用针对多发性骨髓瘤(MM)的FISH检测套餐对富集后的细胞进行遗传学分析。
该套餐包括一个用于检测1号染色体异常的1q探针,以及一个双色探针组合(红色标记D13S319位点,绿色标记LSI 13q34位点),用于同步评估13号染色体相关异常。
图2. 新鲜骨髓样本FISH检测结果
检测结果显示,CD138阳性细胞富集效率较高,荧光信号清晰、背景干扰低,异常信号模式(2R3G)的阳性率为86%,表明可对多发性骨髓瘤细胞进行有效检出。
综上,通过CD138免疫磁珠可以高效富集目标细胞,显著提升FISH检测的准确性与效率。
产品信息
